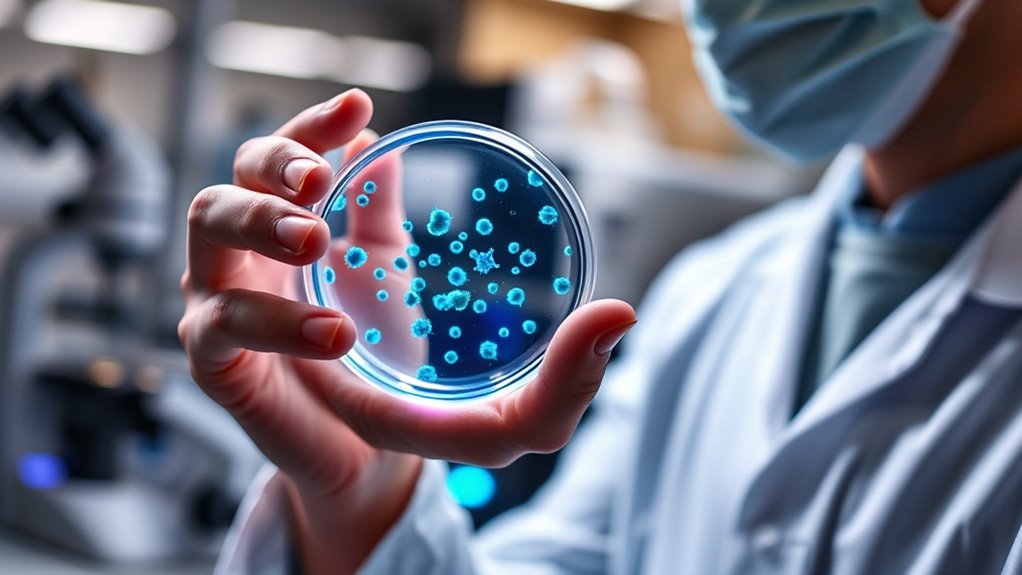

Young immune cell therapy can reverse cognitive decline in mice by boosting their immune system and reducing brain inflammation. By introducing youthful immune cells, this therapy helps clear debris, lower inflammation, and promote neuron growth. As a result, mice show improved memory, learning, and problem-solving abilities. If you want to understand how this innovative approach works and its potential for humans, there’s more to discover about this groundbreaking research.
Key Takeaways
- Transferring young, active immune cells into aged mice improves memory, learning, and problem-solving abilities.
- The therapy reduces brain inflammation and neuronal damage associated with aging.
- It promotes neural connectivity and increases neuroprotective factors in the brain.
- Young immune cells help restore immune balance, supporting brain repair and resilience.
- Results demonstrate immune-based treatment’s potential to reverse age-related cognitive decline in mice.

Young Immune Cell Therapy is revolutionizing how we fight diseases by harnessing the power of youthful, active immune cells. This innovative approach taps into the potential of young immune cells to combat age-related decline, especially in cognitive functions. Researchers have discovered that as we age, our immune system’s efficiency diminishes, leading to increased vulnerability to neurodegenerative conditions and cognitive deterioration. By introducing healthy, youthful immune cells into older mice, scientists are exploring ways to reverse these effects. The process involves isolating immune cells from young donors, then activating and expanding them before delivering them into the bloodstream of aged mice. This method aims to rejuvenate the immune response, enhance brain health, and restore cognitive abilities.
Rejuvenating brain health by boosting youthful immune cells to combat age-related cognitive decline.
The results from these experiments are promising. Mice receiving young immune cells show significant improvements in memory, learning, and problem-solving tasks compared to untreated controls. The therapy appears to reduce inflammation in the brain, a key factor implicated in cognitive decline. Inflammation can damage neurons and interfere with neural communication, but young immune cells seem to modulate this response, promoting a healthier brain environment. Researchers also observe increased growth of neural connections and higher levels of neuroprotective factors in treated mice, suggesting that the therapy not only reduces damage but actively supports brain repair. Additionally, the effectiveness of immune cell therapy may be influenced by the contrast ratio of the environment, which affects how well neural connections can form and function.
You might wonder how exactly young immune cells make such a difference. These cells are more efficient at clearing debris, fighting off infections, and regulating immune responses. When introduced into an older organism, they help restore balance, reducing chronic inflammation that often accompanies aging. They also secrete beneficial compounds that encourage the growth of new neurons and support synaptic plasticity, which underpins learning and memory. The immune cells seem to create a more youthful immune environment, which in turn fosters brain resilience. This approach highlights the broader potential of immune-based therapies in combating age-related neurological decline.
Top picks for "young immune cell"
Open Amazon search results for this keyword.
As an affiliate, we earn on qualifying purchases.
Frequently Asked Questions
Can This Therapy Be Applied to Humans?
Yes, this therapy could potentially be applied to humans, but it’s still in early research stages. You should know that scientists need to conduct extensive clinical trials to guarantee safety and effectiveness in people. While promising results in mice are encouraging, human biology is more complex. If future studies confirm its safety, this therapy might become a viable option to help reverse cognitive decline in humans.
Are There Any Side Effects in Mice?
While the therapy shows promising results, there are minor bumps in the road. In mice, some experience mild, temporary effects like slight changes in activity levels or appetite. These aren’t serious concerns and tend to resolve on their own. Overall, the treatment appears safe, but ongoing studies will help guarantee you’re fully aware of any potential side effects before considering this approach for humans.
How Long Do the Cognitive Improvements Last?
The cognitive improvements from this therapy can last for several weeks to a few months, depending on the individual mouse and treatment specifics. You might notice that the benefits gradually diminish over time, so ongoing treatments could be necessary to maintain the enhanced cognition. Keep in mind that these results are in mice, and the duration may vary if applied to humans. Regular monitoring helps optimize the therapy’s effectiveness.
What Age of Mice Benefits Most From This Therapy?
Think of the mice as aging trees, their branches thinning with time. You’ll find that younger mice, around 6 months old, benefit most from this therapy, as their “roots” are still strong enough to regenerate growth. Older mice, like ancient oaks, struggle to regain full vigor. So, applying this treatment early seals the promise of reversing decline, much like nurturing a sapling before it’s too late.
Is the Treatment Cost-Effective for Large-Scale Use?
You might find that the treatment’s cost-effectiveness for large-scale use depends on factors like production costs, long-term benefits, and healthcare savings. While initial expenses could be high, if the therapy markedly improves cognitive function and reduces age-related healthcare needs, it could become more economical over time. You’ll need to contemplate these variables carefully before determining if implementing this therapy broadly makes financial sense.
Conclusion
Imagine a future where you can turn back the clock on your brain just by harnessing youthful immune cells. This groundbreaking therapy could revolutionize aging, making cognitive decline a thing of the past. With such incredible power in your hands, aging might become just a number, and sharp memory something you can keep forever. It’s like discovering the fountain of youth for your mind—more astonishing than you ever thought possible!